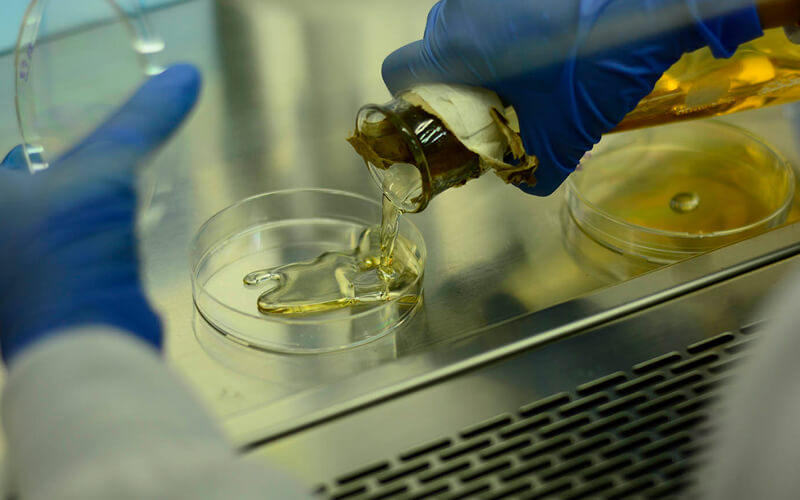
Portada

2026-03-04
Temperatura, tiempo y tipo de alimento definen la seguridad de los empaques plásticos
Aunque los empaques plásticos como el icopor (poliestireno expandido) cumplen un papel fundamental en la conservación, el transporte y la protección de los alimentos, en ciertas condiciones pueden transferir compuestos químicos al producto, un fenómeno conocido como migración. Este proceso no ocurre de manera uniforme: los alimentos grasos, ácidos o sometidos a altas temperaturas pueden favorecer una mayor liberación de sustancias del plástico, por lo que cada caso se debe evaluar según su uso real y no solo en las condiciones ideales de un laboratorio.
En el Laboratorio de Extensión y Asesoría del Departamento de Química de la UNAL este fenómeno se analiza mediante ensayos de migración global y específica. La migración global permite determinar la cantidad total de sustancias que pasan del empaque al alimento, mientras que la específica identifica compuestos particulares que representarían un riesgo para la salud, lo que ofrece una lectura más detallada de la interacción entre el material y el producto.
Para realizar esta pruebas se utilizan simulantes de alimentos —sustancias que reproducen el comportamiento de líquidos, grasas o medios ácidos— con el fin de recrear las condiciones reales de consumo. Estos se someten a distintos escenarios de temperatura y tiempo, como refrigeración, almacenamiento prolongado o calentamiento, lo que permite observar cómo varía la migración según el uso que tendrá el empaque.
“Evaluamos cómo influyen factores como la temperatura, el tiempo de contacto y la naturaleza del alimento en ese proceso de migración, porque no es lo mismo un producto seco que uno graso o ácido. Estos análisis permiten anticipar riesgos y verificar si los materiales cumplen con los límites establecidos por la normativa vigente”, explica la profesora Diana Sinuco León, directora del Laboratorio.
Evaluación técnica define cuándo un empaque es seguro
Uno de los hallazgos más llamativos se dio en el análisis de biberones disponibles en el mercado nacional. En el marco de un trabajo de maestría se evaluó la posible migración de bisfenol A, un compuesto utilizado en algunos plásticos y reconocido por sus efectos potencialmente nocivos para la salud.
“Los resultados mostraron que no todos los productos presentaban migración de esta sustancia, lo que evidencia diferencias en los procesos de fabricación y en la calidad de los materiales utilizados”, anota la profesora Sinuco.
El estudio también permitió identificar un avance importante: varias marcas han mejorado sus tecnologías de producción y han logrado evitar la transferencia de este tipo de compuestos, especialmente en productos destinados al cuidado de bebés, un aspecto crítico por la alta sensibilidad de esta población.
Entre las sustancias que pueden migrar se encuentran ftalatos, bisfenol A o nitrosaminas, compuestos utilizados en la fabricación de plásticos que, en determinadas concentraciones y condiciones. “Por ello es fundamental establecer límites máximos permitidos, ya que su exposición prolongada se ha relacionado con efectos como alteraciones hormonales e incluso con procesos asociados con el desarrollo de algunos tipos de cáncer. Se trata de compuestos no deseados en los empaques, precisamente porque se pueden transferir a los alimentos”, señala la experta.
El control de estos materiales no recae solo en los laboratorios. Los fabricantes envían sus productos para evaluación, pero son ellos quienes deben ajustar las formulaciones. Esto implica modificar los aditivos —sustancias que se incorporan al plástico para darle propiedades como flexibilidad, resistencia o transparencia—, ya que su selección y combinación determinan si estos compuestos pueden migrar o no hacia los alimentos.
Los ensayos no buscan demostrar que todos los empaques son peligrosos, sino establecer en qué condiciones su uso es seguro y en cuáles representaría un riesgo, lo que resulta fundamental para que la industria de alimentos tome decisiones al respecto.
“El Laboratorio cuenta con metodologías estandarizadas y procesos validados que permiten ofrecer resultados confiables. Empresas del sector alimentario acuden a estos análisis para verificar que sus materiales cumplen con los requisitos antes de comercializarlos, lo que convierte estos estudios en un filtro técnico previo a la circulación de los productos en el mercado”, afirma Clemencia Daza, coordinadora de calidad del Laboratorio.
Riesgos asociados con el uso inadecuado de los empaques
Además del análisis técnico, las investigadoras advierten sobre prácticas cotidianas que pueden alterar el comportamiento de los empaques; por ejemplo calentar alimentos en recipientes no diseñados para altas temperaturas, como el icopor, puede favorecer la liberación de sustancias no previstas en condiciones normales de uso.
Así mismo, el uso repetido de empaques diseñados para una sola aplicación puede modificar sus propiedades físicas y químicas, aumentando así la probabilidad de migración de compuestos. Por ejemplo, reutilizar envases plásticos de un solo uso para calentar alimentos en microondas, almacenar comidas calientes, o someterlos a lavados frecuentes puede degradar el material y favorecer la liberación de sustancias hacia los alimentos. También ocurre cuando las botellas desechables se rellenan varias veces o se exponen al sol, lo que altera su estructura. Esto refuerza la importancia de seguir las recomendaciones de uso indicadas por los fabricantes.
Más allá del laboratorio, estas investigaciones aportan información importante para el desarrollo de materiales más seguros y para el fortalecimiento de la regulación. En un contexto de alto consumo de alimentos empacados, entender estas interacciones permite no solo proteger la salud de los consumidores, sino también orientar prácticas industriales más responsables y basadas en evidencia científica.
Si requiere más información sobre el Laboratorio de Extensión y Asesoría, visite: lea-fcbog @unal.edu.co
Las expertas ofrecieron los aportes a este tema en la Agenda Universitaria del programa Análisis UNAL.
Autor

Unimedios | Agencia de Noticias UN
La Unidad de Medios de Comunicación – Unimedios, es la unidad de producción y difusión de la información científica, cultural, investigativa, académica, artística y tecnológica generada por la Universidad Nacional de Colombia y dirigida a la comunidad universitaria y a la sociedad en general. Es una dependencia de nivel nacional, adscrita a la Rectoría que articula los medios de comunicación existentes dentro de la Unidad para velar por el buen nombre e imagen de la Institución, promover y agenciar sus logros e integrarla en su diversidad y con la sociedad a través de sus medios, servicios y productos.